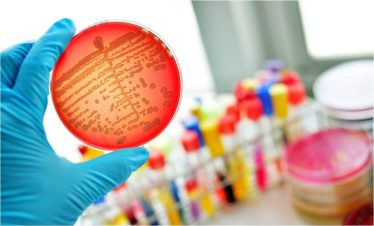

ΕΠΙΣΤΗΜΟΝΙΚΗ ΔΙΑΛΕΞΗ 7/01 "Β-ΑΙΜΟΛΥΤΙΚΟΣ ΣΤΡΕΠΤΟΚΟΚΚΟΣ. ΝΕΟΤΕΡΑ ΔΕΔΟΜΕΝΑ ΣΤΗ ΔΙΑΓΝΩΣΗ ΚΑΙ ΣΤΗΝ ΑΝΤΙΜΕΤΩΠΙΣΗ"
Με επιτυχία διεξήχθη την Τρίτη 7 Ιανουαρίου 2020 στην Κλινική ΡΕΑ, η Επιστημονική Διάλεξη με θέμα: «β-Αιμολυτικός Στρεπτόκοκκος. Νεότερα δεδομένα στη διάγνωση και στην αντιμετώπιση».
Εισηγητής ήταν ο κ. Αποστολακόπουλος Παναγιώτης, Βιοπαθολόγος, Διευθυντής Κεντρικών Εργαστηρίων Κλινικής ΡΕΑ.

Στη διάλεξη προέδρευσε η κα. Κουράκου Ευγενία, Μαιευτήρας Γυναικολόγος, Διευθύνουσα Σύμβουλος ΔΣ Κλινικής ΡΕΑ.







